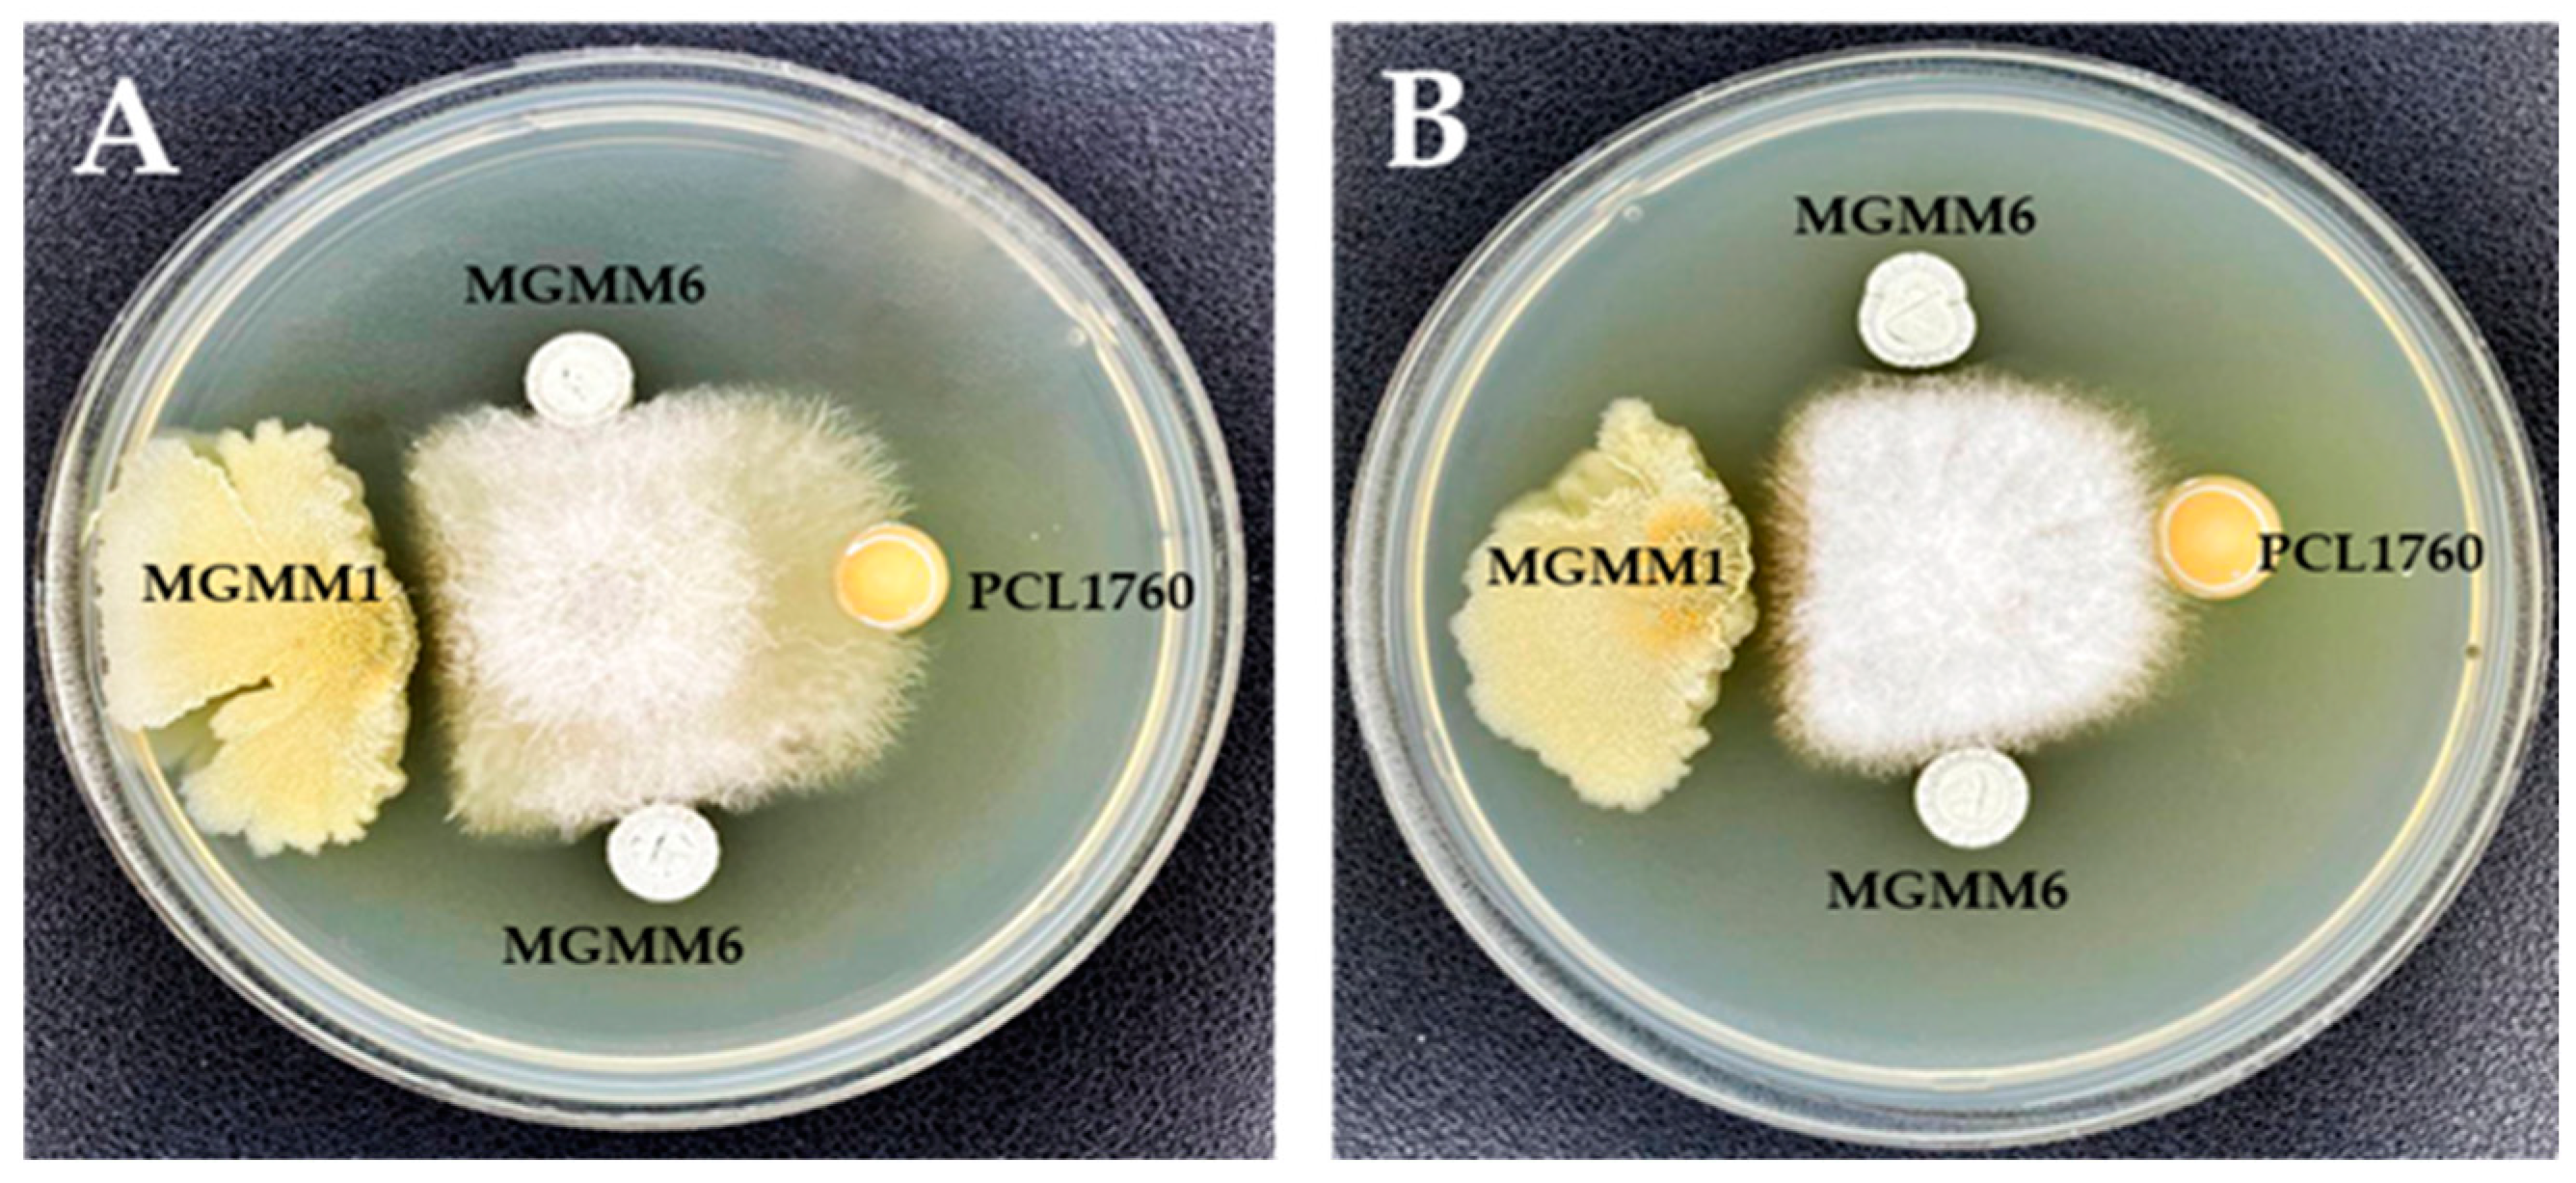

Genomic Insights into the Microbial Agent Streptomyces albidoflavus MGMM6 for Various Biotechnology Applications
Abstract
:1. Introduction
2. Materials and Methods
2.1. Phenotypic Characterization
2.2. Library Construction, Genome Sequencing, and Analysis
2.3. In Silico Identification of Heavy Metal Resistance Genes
2.4. Antibiosis Activity
2.5. Ability of S. albidoflavus MGMM6 to Decolorize and Degrade Dyes
2.6. Statistical Analysis
3. Results
3.1. Phenotypic Characterization and Genome Sequencing Analysis
3.2. Identification of Antimicrobial and Heavy Metal Resistance Genes in S. albidoflavus MGMM6
3.3. Antibiosis Activity
3.4. Dye Decolorization and Degradation Ability
4. Discussion
5. Conclusions
Author Contributions
Funding
Institutional Review Board Statement
Informed Consent Statement
Data Availability Statement
Conflicts of Interest
References
- Dincer, I. Renewable Energy and Sustainable Development: A Crucial Review. Renew. Sustain. Energy Rev. 2000, 4, 157–175. [Google Scholar] [CrossRef]
- Bondarczuk, K.; Markowicz, A.; Piotrowska-Seget, Z. The Urgent Need for Risk Assessment on the Antibiotic Resistance Spread via Sewage Sludge Land Application. Environ. Int. 2016, 87, 49–55. [Google Scholar] [CrossRef]
- Cesare, A.D.; Eckert, E.; Corno, G. Co-Selection of Antibiotic and Heavy Metal Resistance in Freshwater Bacteria. J. Limnol. 2016, 75, 9–66. [Google Scholar] [CrossRef]
- Yang, X.; Wang, J.; Zhao, X.; Wang, Q.; Xue, R. Increasing Manganese Peroxidase Production and Biodecolorization of Triphenylmethane Dyes by Novel Fungal Consortium. Bioresour. Technol. 2011, 102, 10535–10541. [Google Scholar] [CrossRef] [PubMed]
- Yang, Y.; Hu, H.; Wang, G.; Li, Z.; Wang, B.; Jia, X.; Zhao, Y. Removal of Malachite Green from Aqueous Solution by Immobilized Pseudomonas Sp. DY1 with Aspergillus Oryzae. Int. Biodeterior. Biodegrad. 2011, 65, 429–434. [Google Scholar] [CrossRef]
- Valls, M.; de Lorenzo, V. Exploiting the Genetic and Biochemical Capacities of Bacteria for the Remediation of Heavy Metal Pollution. FEMS Microbiol. Rev. 2002, 26, 327–338. [Google Scholar] [CrossRef] [PubMed]
- Álvarez, A.; Catalano, S.A.; Amoroso, M.J. Heavy Metal Resistant Strains Are Widespread along Streptomyces Phylogeny. Mol. Phylogenet. Evol. 2013, 66, 1083–1088. [Google Scholar] [CrossRef] [PubMed]
- Ojuederie, O.B.; Babalola, O.O. Microbial and Plant-Assisted Bioremediation of Heavy Metal Polluted Environments: A Review. Int. J. Environ. Res. Public Health 2017, 14, 1504. [Google Scholar] [CrossRef]
- Gadd, G.M. Metals, minerals and microbes: Geomicrobiology and bioremediation. Microbiology 2010, 156, 609–643. [Google Scholar] [CrossRef]
- Lei, Q.; Zhong, J.; Chen, S.-F.; Wu, S.; Huang, Y.; Guo, P.; Mishra, S.; Bhatt, K.; Chen, S. Microbial Degradation as a Powerful Weapon in the Removal of Sulfonylurea Herbicides. Environ. Res. 2023, 235, 116570. [Google Scholar] [CrossRef]
- Mishra, S.; Huang, Y.; Li, J.; Wu, X.; Zhou, Z.; Lei, Q.; Bhatt, P.; Chen, S. Biofilm-Mediated Bioremediation Is a Powerful Tool for the Removal of Environmental Pollutants. Chemosphere 2022, 294, 133609. [Google Scholar] [CrossRef] [PubMed]
- Rastogi, R.P.; Sinha, R.P. Biotechnological and Industrial Significance of Cyanobacterial Secondary Metabolites. Biotechnol. Adv. 2009, 27, 521–539. [Google Scholar] [CrossRef] [PubMed]
- Yadav, A.N. Microbial biotechnology for bioprospecting of microbial bioactive compounds and secondary metabolites. J. Appl. Biol. Biotechnol. 2021, 9, 1–6. [Google Scholar] [CrossRef]
- Bugg, T.D.; Ahmad, M.; Hardiman, E.M.; Singh, R. The Emerging Role for Bacteria in Lignin Degradation and Bio-Product Formation. Curr. Opin. Biotechnol. 2011, 22, 394–400. [Google Scholar] [CrossRef] [PubMed]
- Chen, S.; Geng, P.; Xiao, Y.; Hu, M. Bioremediation of β-Cypermethrin and 3-Phenoxybenzaldehyde Contaminated Soils Using Streptomyces Aureus HP-S-01. Appl. Microbiol. Biotechnol. 2012, 94, 505–515. [Google Scholar] [CrossRef] [PubMed]
- Bérdy, J. Thoughts and Facts about Antibiotics: Where We Are Now and Where We Are Heading. J. Antibiot. 2012, 65, 385–395. [Google Scholar] [CrossRef]
- Rong, X.; Guo, Y.; Huang, Y. Proposal to Reclassify the Streptomyces albidoflavus Clade on the Basis of Multilocus Sequence Analysis and DNA–DNA Hybridization, and Taxonomic Elucidation of Streptomyces griseus Subsp. Solvifaciens. Syst. Appl. Microbiol. 2009, 32, 314–322. [Google Scholar] [CrossRef]
- Seipke, R.F.; Hutchings, M.I. The Regulation and Biosynthesis of Antimycins. Beilstein J. Org. Chem. 2013, 9, 2556–2563. [Google Scholar] [CrossRef]
- Du, Y.; Wang, T.; Jiang, J.; Wang, Y.; Lv, C.; Sun, K.; Sun, J.; Yan, B.; Kang, C.; Guo, L. Biological Control and Plant Growth Promotion Properties of Streptomyces Albidoflavus St-220 Isolated from Salvia Miltiorrhiza Rhizosphere. Front. Plant Sci. 2022, 13, 976813. [Google Scholar] [CrossRef]
- Carlucci, A.; Raimondo, M.L.; Colucci, D.; Lops, F. Streptomyces albidoflavus Strain CARA17 as a Biocontrol Agent against Fungal Soil-Borne Pathogens of Fennel Plants. Plants 2022, 11, 1420. [Google Scholar] [CrossRef]
- Green, M.R.; Sambrook, J. Isolation of High-Molecular-Weight DNA Using Organic Solvents. Cold Spring Harb. Protoc. 2017, 2017, pdb.prot093450. [Google Scholar] [CrossRef] [PubMed]
- Brown, J.; Pirrung, M.; McCue, L.A. FQC Dashboard: Integrates FastQC Results into a Web-Based, Interactive, and Extensible FASTQ Quality Control Tool. Bioinformatics 2017, 33, 3137–3139. [Google Scholar] [CrossRef] [PubMed]
- Chen, S.; Zhou, Y.; Chen, Y.; Gu, J. Fastp: An Ultra-Fast All-in-One FASTQ Preprocessor. Bioinformatics 2018, 34, i884–i890. [Google Scholar] [CrossRef] [PubMed]
- Souvorov, A.; Agarwala, R.; Lipman, D.J. SKESA: Strategic k-Mer Extension for Scrupulous Assemblies. Genome Biol. 2018, 19, 153. [Google Scholar] [CrossRef] [PubMed]
- Wick, R.R.; Judd, L.M.; Gorrie, C.L.; Holt, K.E. Unicycler: Resolving Bacterial Genome Assemblies from Short and Long Sequencing Reads. PLoS Comput. Biol. 2017, 13, e1005595. [Google Scholar] [CrossRef]
- Bankevich, A.; Nurk, S.; Antipov, D.; Gurevich, A.A.; Dvorkin, M.; Kulikov, A.S.; Lesin, V.M.; Nikolenko, S.I.; Pham, S.; Prjibelski, A.D.; et al. SPAdes: A New Genome Assembly Algorithm and Its Applications to Single-Cell Sequencing. J. Comput. Biol. 2012, 19, 455–477. [Google Scholar] [CrossRef]
- Chen, K.-T.; Lu, C.L. CSAR-Web: A Web Server of Contig Scaffolding Using Algebraic Rearrangements. Nucleic Acids Res. 2018, 46, W55–W59. [Google Scholar] [CrossRef]
- De Sa, P.H.; Miranda, F.; Veras, A.; de Melo, D.M.; Soares, S.; Pinheiro, K.; Ramos, R.T. GapBlaster—A graphical gap filler for prokaryote genomes. PLoS ONE 2016, 11, e0155327. [Google Scholar] [CrossRef]
- Antipov, D.; Hartwick, N.; Shen, M.; Raiko, M.; Lapidus, A.; Pevzner, P.A. plasmidSPAdes: Assembling Plasmids from Whole Genome Sequencing Data. Bioinformatics 2016, 32, 3380–3387. [Google Scholar] [CrossRef]
- Robertson, J.; Nash, J.H.E. MOB-Suite: Software Tools for Clustering, Reconstruction and Typing of Plasmids from Draft Assemblies. Microb. Genom. 2018, 4, e000206. [Google Scholar] [CrossRef]
- Robertson, J.; Bessonov, K.; Schonfeld, J.; Nash, J.H.E. Universal Whole-Sequence-Based Plasmid Typing and Its Utility to Prediction of Host Range and Epidemiological Surveillance. Microb. Genom. 2020, 6, mgen000435. [Google Scholar] [CrossRef] [PubMed]
- Tatusova, T.; DiCuccio, M.; Badretdin, A.; Chetvernin, V.; Nawrocki, E.P.; Zaslavsky, L.; Lomsadze, A.; Pruitt, K.D.; Borodovsky, M.; Ostell, J. NCBI Prokaryotic Genome Annotation Pipeline. Nucleic Acids Res. 2016, 44, 6614–6624. [Google Scholar] [CrossRef]
- Schwengers, O.; Jelonek, L.; Dieckmann, M.A.; Beyvers, S.; Blom, J.; Goesmann, A. Bakta: Rapid and Standardized Annotation of Bacterial Genomes via Alignment-Free Sequence Identification. Microb. Genom. 2021, 7, 000685. [Google Scholar] [CrossRef] [PubMed]
- Parks, D.H.; Imelfort, M.; Skennerton, C.T.; Hugenholtz, P.; Tyson, G.W. CheckM: Assessing the Quality of Microbial Genomes Recovered from Isolates, Single Cells, and Metagenomes. Genome Res. 2015, 25, 1043–1055. [Google Scholar] [CrossRef] [PubMed]
- McArthur, A.G.; Waglechner, N.; Nizam, F.; Yan, A.; Azad, M.A.; Baylay, A.J.; Bhullar, K.; Canova, M.J.; De Pascale, G.; Ejim, L.; et al. The Comprehensive Antibiotic Resistance Database. Antimicrob. Agents Chemother. 2013, 57, 3348–3357. [Google Scholar] [CrossRef] [PubMed]
- Blin, K.; Shaw, S.; Augustijn, H.E.; Reitz, Z.L.; Biermann, F.; Alanjary, M.; Fetter, A.; Terlouw, B.R.; Metcalf, W.W.; Helfrich, E.J.N.; et al. antiSMASH 7.0: New and Improved Predictions for Detection, Regulation, Chemical Structures and Visualisation. Nucleic Acids Res. 2023, 51, W46–W50. [Google Scholar] [CrossRef]
- Brown, C.L.; Mullet, J.; Hindi, F.; Stoll, J.E.; Gupta, S.; Choi, M.; Keenum, I.; Vikesland, P.; Pruden, A.; Zhang, L. mobileOG-Db: A Manually Curated Database of Protein Families Mediating the Life Cycle of Bacterial Mobile Genetic Elements. Appl. Environ. Microbiol. 2022, 88, e00991-22. [Google Scholar] [CrossRef]
- Pal, C.; Bengtsson-Palme, J.; Rensing, C.; Kristiansson, E.; Larsson, D.G.J. BacMet: Antibacterial Biocide and Metal Resistance Genes Database. Nucleic Acids Res. 2014, 42, D737–D743. [Google Scholar] [CrossRef]
- Feldgarden, M.; Brover, V.; Gonzalez-Escalona, N.; Frye, J.G.; Haendiges, J.; Haft, D.H.; Hoffmann, M.; Pettengill, J.B.; Prasad, A.B.; Tillman, G.E.; et al. AMRFinderPlus and the Reference Gene Catalog Facilitate Examination of the Genomic Links among Antimicrobial Resistance, Stress Response, and Virulence. Sci. Rep. 2021, 11, 12728. [Google Scholar] [CrossRef]
- Bonev, B.; Hooper, J.; Parisot, J. Principles of Assessing Bacterial Susceptibility to Antibiotics Using the Agar Diffusion Method. J. Antimicrob. Chemother. 2008, 61, 1295–1301. [Google Scholar] [CrossRef]
- Aravind, P.; Selvaraj, H.; Ferro, S.; Sundaram, M. An Integrated (Electro- and Bio-Oxidation) Approach for Remediation of Industrial Wastewater Containing Azo-Dyes: Understanding the Degradation Mechanism and Toxicity Assessment. J. Hazard. Mater. 2016, 318, 203–215. [Google Scholar] [CrossRef] [PubMed]
- Diabankana, R.G.C.; Afordoanyi, D.M.; Safin, R.I.; Nizamov, R.M.; Karimova, L.Z.; Validov, S.Z. Antifungal Properties, Abiotic Stress Resistance, and Biocontrol Ability of Bacillus mojavensis PS17. Curr. Microbiol. 2021, 78, 3124–3132. [Google Scholar] [CrossRef] [PubMed]
- Czaja, W.; Krystynowicz, A.; Bielecki, S.; Brown, R.M. Microbial Cellulose—The Natural Power to Heal Wounds. Biomaterials 2006, 27, 145–151. [Google Scholar] [CrossRef] [PubMed]
- Sen, R. Biotechnology in Petroleum Recovery: The Microbial EOR. Prog. Energy Combust. Sci. 2008, 34, 714–724. [Google Scholar] [CrossRef]
- Yadav, A.N.; Singh, S.; Mishra, S.; Gupta, A. Recent Advancement in White Biotechnology through Fungi; Springer International Publishing: Cham, Switzerland, 2019; p. 528. [Google Scholar]
- Haeder, S.; Wirth, R.; Herz, H.; Spiteller, D. Candicidin-Producing Streptomyces Support Leaf-Cutting Ants to Protect Their Fungus Garden against the Pathogenic Fungus Escovopsis. Proc. Natl. Acad Sci. USA 2009, 106, 4742–4746. [Google Scholar] [CrossRef] [PubMed]
- Dias, D.A.; Urban, S.; Roessner, U. A Historical Overview of Natural Products in Drug Discovery. Metabolites 2012, 2, 303–336. [Google Scholar] [CrossRef] [PubMed]
- Marcone, G.L.; Binda, E.; Berini, F.; Marinelli, F. Old and New Glycopeptide Antibiotics: From Product to Gene and Back in the Post-Genomic Era. Biotechnol. Adv. 2018, 36, 534–554. [Google Scholar] [CrossRef]
- Pishchany, G.; Mevers, E.; Ndousse-Fetter, S.; Horvath, D.J.; Paludo, C.R.; Silva-Junior, E.A.; Koren, S.; Skaar, E.P.; Clardy, J.; Kolter, R. Amycomicin Is a Potent and Specific Antibiotic Discovered with a Targeted Interaction Screen. Proc. Natl. Acad. Sci. USA 2018, 115, 10124–10129. [Google Scholar] [CrossRef]
- Zhang, D.; Lu, Y.; Chen, H.; Wu, C.; Zhang, H.; Chen, L.; Chen, X. Antifungal Peptides Produced by Actinomycetes and Their Biological Activities against Plant Diseases. J. Antibiot. 2020, 73, 265–282. [Google Scholar] [CrossRef]
- Shi, P.; Li, Y.; Zhu, J.; Shen, Y.; Wang, H. Targeted Discovery of the Polyene Macrolide Hexacosalactone A from Streptomyces by Reporter-Guided Selection of Fermentation Media. J. Nat. Prod. 2021, 84, 1924–1929. [Google Scholar] [CrossRef]
- Takada, K.; Ninomiya, A.; Naruse, M.; Sun, Y.; Miyazaki, M.; Nogi, Y.; Okada, S.; Matsunaga, S. Surugamides A-E, Cyclic Octapeptides with Four D-Amino Acid Residues, from a Marine Streptomyces sp.: LC-MS-Aided Inspection of Partial Hydrolysates for the Distinction of D- and L-Amino Acid Residues in the Sequence. J. Org. Chem. 2013, 78, 6746–6750. [Google Scholar] [CrossRef] [PubMed]
- Xu, F.; Nazari, B.; Moon, K.; Bushin, L.B.; Seyedsayamdost, M.R. Discovery of a Cryptic Antifungal Compound from Streptomyces Albus J1074 Using High-Throughput Elicitor Screens. J. Am. Chem. Soc. 2017, 139, 9203–9212. [Google Scholar] [CrossRef]
- Codd, R.; Richardson-Sanchez, T.; Telfer, T.J.; Gotsbacher, M.P. Advances in the Chemical Biology of Desferrioxamine B. ACS Chem. Biol. 2018, 13, 11–25. [Google Scholar] [CrossRef] [PubMed]
- Bellotti, D.; Remelli, M. Deferoxamine B: A Natural, Excellent and Versatile Metal Chelator. Molecules 2021, 26, 3255. [Google Scholar] [CrossRef] [PubMed]
- Kido, G.S.; Spyhalski, E. Antimycin A, an Antibiotic with Insecticidal and Miticidal Properties. Science 1950, 112, 172–173. [Google Scholar] [CrossRef] [PubMed]
- Luo, Y.; Huang, H.; Liang, J.; Wang, M.; Lu, L.; Shao, Z.; Cobb, R.E.; Zhao, H. Activation and Characterization of a Cryptic Polycyclic Tetramate Macrolactam Biosynthetic Gene Cluster. Nat. Commun. 2013, 4, 2894. [Google Scholar] [CrossRef] [PubMed]
- Trabelsi, D.; Mhamdi, R. Microbial Inoculants and Their Impact on Soil Microbial Communities: A Review. Biomed. Res. Int. 2013, 2013, 863240. [Google Scholar] [CrossRef] [PubMed]
- Bai, G.; Shaner, G. Management and resistance in wheat and barley to Fusarium head blight. Annu. Rev. Phytopathol. 2004, 42, 135–161. [Google Scholar] [CrossRef]
- Oldenburg, E.; Höppner, F.; Ellner, F.; Weinert, J. Fusarium diseases of maize associated with mycotoxin contamination of agricultural products intended to be used for food and feed. Mycotoxin. Res. 2017, 33, 167–182. [Google Scholar] [CrossRef]
- Anand, G.; Rajeshkumar, K.C. Challenges and Threats Posed by Plant Pathogenic Fungi on Agricultural Productivity and Economy. In Fungal Diversity, Ecology and Control Management; Springer Nature Singapore: Singapore, 2022; pp. 483–493. [Google Scholar] [CrossRef]
- Tekauz, A.; McCallum, B.; Gilbert, J. Fusarium head blight of barley in western Canada. Can. J. Plant Pathol. 2000, 22, 9–16. [Google Scholar] [CrossRef]
- Mudili, V.; Siddaih, C.N.; Nagesh, M.; Garapati, P.; Naveen Kumar, K.; Murali, H.S.; Yli Mattila, T.; Batra, H.V. Mould incidence and mycotoxin contamination in freshly harvested maize kernels originated from India. J. Sci. Food Agric. 2014, 94, 2674–2683. [Google Scholar] [CrossRef] [PubMed]
- Nelson, M.S.; Sadowsky, M.J. Secretion Systems and Signal Exchange between Nitrogen-Fixing Rhizobia and Legumes. Front. Plant Sci. 2015, 6, 491. [Google Scholar] [CrossRef] [PubMed]
- Massalha, H.; Korenblum, E.; Tholl, D.; Aharoni, A. Small Molecules Below-Ground: The Role of Specialized Metabolites in the Rhizosphere. Plant J. 2017, 90, 788–807. [Google Scholar] [CrossRef] [PubMed]
- Castillo, M.A.; Felis, N.; Aragón, P.; Cuesta, G.; Sabater, C. Biodegradation of the Herbicide Diuron by Streptomycetes Isolated from Soil. Int. Biodeterior. Biodegrad. 2006, 58, 196–202. [Google Scholar] [CrossRef]
- Seo, J.-S.; Keum, Y.-S.; Li, Q.X. Bacterial Degradation of Aromatic Compounds. Int. J. Environ. Res. Public Health 2009, 6, 278–309. [Google Scholar] [CrossRef] [PubMed]
- Jaouadi, B.; Rekik, H.; Badis, A.; Jaouadi, N.Z.; Belhoul, M.; Hmidi, M.; Kourdali, S.; Fodil, D.; Bejar, S. Production, Purification, and Characterization of a Highly Thermostable and Humic Acid Biodegrading Peroxidase from a Decolorizing Streptomyces albidoflavus strain TN644 Isolated from a Tunisian off-Shore Oil Field. Int. Biodeterior. Biodegrad. 2014, 90, 36–44. [Google Scholar] [CrossRef]
- Tian, M.; Du, D.; Zhou, W.; Zeng, X.; Cheng, G. Phenol Degradation and Genotypic Analysis of Dioxygenase Genes in Bacteria Isolated from Sediments. Braz. J. Microbiol. 2016, 48, 305–313. [Google Scholar] [CrossRef]
- Wang, S.-S.; Ning, Y.-J.; Wang, S.-N.; Zhang, J.; Zhang, G.-Q.; Chen, Q.-J. Purification, Characterization, and Cloning of an Extracellular Laccase with Potent Dye Decolorizing Ability from White Rot Fungus Cerrena Unicolor GSM-01. Int. J. Biol. Macromol. 2017, 95, 920–927. [Google Scholar] [CrossRef]
- Murugesan, K.; Nam, I.-H.; Kim, Y.-M.; Chang, Y.-S. Decolorization of Reactive Dyes by a Thermostable Laccase Produced by Ganoderma lucidum in Solid State Culture. Enzyme Microb. 2007, 40, 1662–1672. [Google Scholar] [CrossRef]
- Zhou, N.; Wang, J.; Wang, W.; Wu, X. Purification, Characterization, and Catalytic Mechanism of N-Isopropylammelide Isopropylaminohydrolase (AtzC) Involved in the Degradation of s-Triazine Herbicides. Environ. Pollut. 2021, 268, 115803. [Google Scholar] [CrossRef]
- Musengi, A.; Durrell, K.; Prins, A.; Khan, N.; Agunbiade, M.; Kudanga, T.; Kirby-McCullough, B.; Pletschke, B.I.; Burton, S.G.; Le Roes-Hill, M. Production and Characterisation of a Novel Actinobacterial DyP-Type Peroxidase and Its Application in Coupling of Phenolic Monomers. Enzyme Microb. 2020, 141, 109654. [Google Scholar] [CrossRef] [PubMed]
- Alaidaroos, B.A. Improvement of Phenol and Heavy Metal Removal by Streptomyces flavabus BA4 Used for Wastewater Treatments. Eur. Online J. Nat. Soc. 2022, 11, 837–851. [Google Scholar]
- Costanzo, S.D.; Murby, J.; Bates, J. Ecosystem Response to Antibiotics Entering the Aquatic Environment. Mar. Pollut. Bull. 2005, 51, 218–223. [Google Scholar] [CrossRef] [PubMed]
- Vittoria Pinna, M.; Castaldi, P.; Deiana, P.; Pusino, A.; Garau, G. Sorption Behavior of Sulfamethazine on Unamended and Manure-Amended Soils and Short-Term Impact on Soil Microbial Community. Ecotoxicol. Environ. Saf. 2012, 84, 234–242. [Google Scholar] [CrossRef] [PubMed]
- Proia, L.; Lupini, G.; Osorio, V.; Pérez, S.; Barceló, D.; Schwartz, T.; Amalfitano, S.; Fazi, S.; Romaní, A.M.; Sabater, S. Response of Biofilm Bacterial Communities to Antibiotic Pollutants in a Mediterranean River. Chemosphere 2013, 92, 1126–1135. [Google Scholar] [CrossRef]
- Cycoń, M.; Mrozik, A.; Piotrowska-Seget, Z. Antibiotics in the soil environment-degradation and their impact on microbial activity and diversity. Front. Microbiol. 2019, 10, 338. [Google Scholar] [CrossRef] [PubMed]
- Liu, F.; Ying, G.-G.; Tao, R.; Zhao, J.-L.; Yang, J.-F.; Zhao, L.-F. Effects of Six Selected Antibiotics on Plant Growth and Soil Microbial and Enzymatic Activities. Environ. Pollut. 2009, 157, 1636–1642. [Google Scholar] [CrossRef] [PubMed]
- Shan, J.; Yang, P.; Rahman, M.M.; Shang, X.; Yan, X. Tetracycline and Sulfamethazine Alter Dissimilatory Nitrate Reduction Processes and Increase N2O Release in Rice Fields. Environ. Pollut. 2018, 242, 788–796. [Google Scholar] [CrossRef]
- Oliver, K.R.; Greene, W.K. Transposable Elements: Powerful Facilitators of Evolution. Bioessays 2009, 31, 703–714. [Google Scholar] [CrossRef]
- Schubert, I.; Vu, G.T.H. Genome Stability and Evolution: Attempting a Holistic View. Trends Plant Sci. 2016, 21, 749–757. [Google Scholar] [CrossRef]
- Mitra, S.; Chakraborty, A.J.; Tareq, A.M.; Emran, T.B.; Nainu, F.; Khusro, A.; Idris, A.M.; Khandaker, M.U.; Osman, H.; Alhumaydhi, F.A.; et al. Impact of Heavy Metals on the Environment and Human Health: Novel Therapeutic Insights to Counter the Toxicity. J. King Saud Univ. Sci. 2022, 34, 101865. [Google Scholar] [CrossRef]
- Wu, X.; Cobbina, S.J.; Mao, G.; Xu, H.; Zhang, Z.; Yang, L. A Review of Toxicity and Mechanisms of Individual and Mixtures of Heavy Metals in the Environment. Environ. Sci. Pollut. Res. Int. 2016, 23, 8244–8259. [Google Scholar] [CrossRef] [PubMed]
- Haider, F.U.; Liqun, C.; Coulter, J.A.; Cheema, S.A.; Wu, J.; Zhang, R.; Wenjun, M.; Farooq, M. Cadmium Toxicity in Plants: Impacts and Remediation Strategies. Ecotoxicol. Environ. Saf. 2021, 211, 111887. [Google Scholar] [CrossRef] [PubMed]
- de Mora, A.P.; Ortega-Calvo, J.J.; Cabrera, F.; Madejón, E. Changes in Enzyme Activities and Microbial Biomass after “in Situ” Remediation of a Heavy Metal-Contaminated Soil. Appl. Soil. Ecol. 2005, 28, 125–137. [Google Scholar] [CrossRef]
- Rana, A.; Sindhu, M.; Kumar, A.; Dhaka, R.K.; Chahar, M.; Singh, S.; Nain, L. Restoration of Heavy Metal-Contaminated Soil and Water through Biosorbents: A Review of Current Understanding and Future Challenges. Physiol. Plant 2021, 173, 394–417. [Google Scholar] [CrossRef]
- Kaliyaraj, D.; Rajendran, M.; Angamuthu, V.; Antony, A.R.; Kaari, M.; Thangavel, S.; Venugopal, G.; Joseph, J.; Manikkam, R. Bioleaching of Heavy Metals from Printed Circuit Board (PCB) by Streptomyces albidoflavus TN10 Isolated from Insect Nest. Bioresour. Bioprocess. 2019, 6, 47. [Google Scholar] [CrossRef]
- Hussain, T.; Akthar, N.; Aminedi, R.; Danish, M.; Nishat, Y.; Patel, S. Role of the Potent Microbial Based Bioagents and Their Emerging Strategies for the Ecofriendly Management of Agricultural Phytopathogens. In Natural Bioactive Products in Sustainable Agriculture; Singh, J., Yadav, A.N., Eds.; Springer: Singapore, 2020; pp. 45–66. ISBN 9789811530241. [Google Scholar] [CrossRef]

| Assembly | |
|---|---|
| Number of contigs (≥1000 bp) | 165 |
| Total length (≥0 bp) | 6,955,497 |
| Total length (≥1000 bp) | 6,942,569 |
| Number of contigs | 176 |
| Largest contig | 236,127 |
| Total length | 6,950,511 |
| GC (%) | 73.38 |
| N50 | 80,168 |
| N90 | 20,631 |
| L50 | 30 |
| L90 | 96 |
| Annotation | |
| Genome Size | 6,932,303 bp |
| Genes (total) | 6024 |
| CDSs (total) | 5955 |
| Genes (coding) | 5851 |
| CDSs (with protein) | 5851 |
| Genes (RNA) | 69 |
| tRNAs | 63 |
| Pseudo Genes (total) | 104 |
| Completeness | 99.34% |
| Contamination | 1.01% |
| KEGG Map | Distinct ECs | S. albidoflavus MGMM6 |
|---|---|---|
| Cis and trans 1,3-dichloropropene | 4 | 4 (100%) |
| 2,4-Dichlorobenzoate degradation | 29 | 2 (6.9%) |
| Benzoate degradation via hydroxylation | 50 | 10 (20.0%) |
| Naphthalene and anthracene degradation | 22 | 5 (22.7%) |
| gamma-Hexachlorocyclohexane degradation | 28 | 5 (17.9%) |
| Benzoate degradation via CoA ligation | 44 | 15 (34.1%) |
| Benzoate degradation via hydroxylation | 50 | 10 (20.0%) |
| Biphenyl degradation | 13 | 2 (15.4%) |
| Toluene and xylene degradation | 23 | 2 (8.7%) |
| Ethylbenzene degradation | 11 | 3(27.3%) |
| 1,1,2,2-tetrachloroethane degradation | 7 | 1 (14.3%) |
| Trinitrotoluene degradation | 7 | 2(28.6%) |
| Fluorobenzoate degradation | 10 | 1 (10.0%) |
| 1- and 2-Methylnaphthalene degradation | 17 | 7 (41.2%) |
| Metabolism of xenobiotics by cytochrome P450 | 7 | 3 (42.9%) |
| Glycosaminoglycan degradation | 16 | 4 (25.0%) |
| Fluorene degradation | 13 | 2 (15.4%) |
| KEGG Map | Distinct ECs | S. albidoflavus MGMM6 |
|---|---|---|
| Brassinosteroid biosynthesis | 3 | 2 (66.7%) |
| Biosynthesis of plant hormones | 131 | 74 (56.5%) |
| Region | Type | Most Similar Known Cluster | Representative Class | Similarity |
|---|---|---|---|---|
| 1 | terpene, NRPS, NRPS-like | valinomycin/montanastatin | NRP + Saccharide: Hybrid/tailoring saccharide | 13% |
| 2 | T1PKS,NRPS | SGR PTMs/SGR PTM Compound b/SGR PTM Compound c/SGR PTM Compound d | NRP + Polyketide | 100% |
| 3 | terpene | hopene | Terpene | 76% |
| 4 | RiPP-like | hexacosalactone A | Other | 4% |
| 5 | NRPS | cyclofaulknamycin | Polyketide | 100% |
| 6 | NI-siderophore | synechobactin C9/C11/13/14/16/A/B/C | Other | 9% |
| 7 | terpene | geosmin | Terpene | 100% |
| 8 | terpene | Julichrome Q3-3/Q3-5 | Polyketide | 25% |
| 9 | thiopeptide, LAP, RRE-containing | fluostatins M-Q | Polyketide | 4% |
| 10 | NRPS-like | minimycin | NRP + Saccharide | 80% |
| 11 | RiPP-like, terpene | isorenieratene | Terpene | 75% |
| 12 | RiPP-like, T3PKS | streptavidin | RiPP: Other | 75% |
| 13 | T1PKS,NRPS-like | candicidin | NRP + Polyketide | 95% |
| 14 | T1PKS,NRPS,lanthipeptide-class-ii,NRPS-like | antimycin | NRP:Cyclic depsipeptide+Polyketide:Modultype I polyketide | 100% |
| 15 | ectoine | ectoine | Other | 100% |
| 16 | lanthipeptide-class-iii | AmfS | RiPP: Lanthipeptide | 80% |
| 17 | NRPS, T2PKS | fredericamycin A | Polyketide: Type II polyketide | 96% |
| 18 | NRPS, LAP | surugamide A/surugamide D | NRP | 95% |
| 19 | NRPS | dudomycin A | NRP | 17% |
| 20 | NI-siderophore | desferrioxamin B | Other | 100% |
Disclaimer/Publisher’s Note: The statements, opinions and data contained in all publications are solely those of the individual author(s) and contributor(s) and not of MDPI and/or the editor(s). MDPI and/or the editor(s) disclaim responsibility for any injury to people or property resulting from any ideas, methods, instructions or products referred to in the content. |
© 2023 by the authors. Licensee MDPI, Basel, Switzerland. This article is an open access article distributed under the terms and conditions of the Creative Commons Attribution (CC BY) license (https://creativecommons.org/licenses/by/4.0/).
Share and Cite
Diabankana, R.G.C.; Frolov, M.; Keremli, S.; Validov, S.Z.; Afordoanyi, D.M. Genomic Insights into the Microbial Agent Streptomyces albidoflavus MGMM6 for Various Biotechnology Applications. Microorganisms 2023, 11, 2872. https://doi.org/10.3390/microorganisms11122872
Diabankana RGC, Frolov M, Keremli S, Validov SZ, Afordoanyi DM. Genomic Insights into the Microbial Agent Streptomyces albidoflavus MGMM6 for Various Biotechnology Applications. Microorganisms. 2023; 11(12):2872. https://doi.org/10.3390/microorganisms11122872
Chicago/Turabian StyleDiabankana, Roderic Gilles Claret, Mikhail Frolov, Saparmyradov Keremli, Shamil Zavdatovich Validov, and Daniel Mawuena Afordoanyi. 2023. "Genomic Insights into the Microbial Agent Streptomyces albidoflavus MGMM6 for Various Biotechnology Applications" Microorganisms 11, no. 12: 2872. https://doi.org/10.3390/microorganisms11122872
APA StyleDiabankana, R. G. C., Frolov, M., Keremli, S., Validov, S. Z., & Afordoanyi, D. M. (2023). Genomic Insights into the Microbial Agent Streptomyces albidoflavus MGMM6 for Various Biotechnology Applications. Microorganisms, 11(12), 2872. https://doi.org/10.3390/microorganisms11122872

